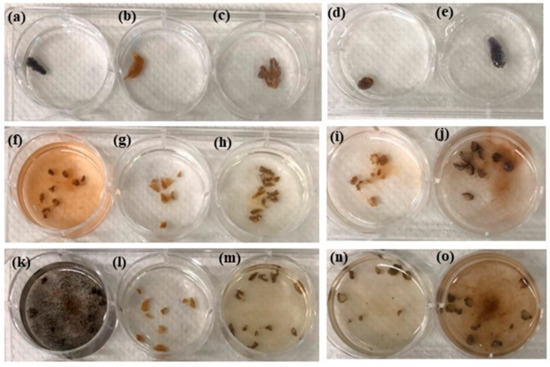

Abstract
Coral reefs are the most diverse and productive marine ecosystems on earth. The National Museum of Marine Biology and Aquarium has cultured more than 35 species of corals for research. When we conducted the asexual propagation of corals, the octocoral Sinularia flexibilis released a black pigment that stained the operator’s hands black. This is the first reported case of the skin being dyed black while propagating corals. We quantified the blackness of the stain by using the RGB value of the color. The longer the coral contacted the skin, the darker the skin became. Incubating the tentacles of S. flexibilis in high-salinity filtered seawater increased the amount of the black pigment released. However, collecting 100% of the black pigment was exceedingly challenging because it was very sticky and was constantly entangled with Symbiodiniaceae. Furthermore, we were unable to identify any solvents that could dissolve the pigment. The structure and function of the black pigment merit further study as it has the potential to become a new black dye for human industries.
1. Introduction
Coral reefs are the largest living structures built by modular, colonial organisms in the world. They have incredibly high biodiversity and are paramount in providing the habitat structure, food sources, and settlement cues that many marine organisms depend on to survive and reproduce [1]. The aquaculture of corals accelerates growth rates, decreases mortality, increases coral population, reduces wild coral harvest for ornamental trade, and shows considerable promise for restoring reefs and preserving biodiversity [2]. The National Museum of Marine Biology and Aquarium (NMMBA) is a government-funded museum focusing on coral conservation in Taiwan. We are devoted to the development of coral farms and cultured corals, with more than 35 species and 27,500 colonies for research. When we were performing asexual coral propagation, we found that the operator’s hand was turned black by the ramet of certain types of octocoral. There have been no such reports in the past. This is the first reported case of the skin being dyed black while propagating corals.
Many studies have investigated the pigments extracted from marine organisms [3,4,5,6,7,8,9,10], including Gorgonian, Asteroidea, and Muricidae. These pigments are mostly bright and colorful, such as blue, purple, bluish violet, yellow, and orange. Melanin pigment production from various marine species is commonly present in algae, fungi, bacteria, cephalopods, and sea cucumbers [11]. Some reports have mentioned that corals can activate a melanin-synthesis pathway in their innate immune system, but the melanin only exists in tissues and is not secreted out [12]. In this article, we present a special black pigment released from an octocoral that dyed the skin black.
2. Materials and Methods
2.1. Reagents
Filtered seawater (FSW) was prepared by filtering natural seawater through a filter unit (0.22 µm pore size). High-salinity FSW (60‰) was obtained by adding sodium chloride and the salinity was measured with a refractometer, indicating an accuracy of ±0.2%.
2.2. Quantification of the Stains
We took pictures of the operator’s hands with a camera (Nikon D7500, Nikon Corporation, Tokyo, Japan) in a photography lightbox (40 cm × 40 cm × 40 cm) with two LED light sources above the lightbox (each light had 42 white 5 mm light-emitting diodes (EVERLIGHT Electronics Co., Ltd., Taipei, Taiwan) and a power supply of DC 24V/2A). The illumination of the photo’s area was 30 µmol/m2/s. The camera system comprised commercial-grade digital single-lens reflex camera, Nikon D7500 (Nikon Co.) with an AF-P Nikkor 18–55 mm lens (Nikon Co.) and a JJC wired remote shutter release (S controller, JJC Photography Equipment Co., Ltd., Shenzhen, China). The photographed images were transformed into a standard RGB color model and compressed into a JPG file format. The photographic system was operated in manual mode using a light sensitivity of ISO 400, a shutter speed of 1/125 s, an aperture of f/8, and an image size of 1856 × 2784 pixels. Before taking the pictures, we used a grayscale card (Tiffen, Hauppauge, New York, NY, USA) to correct the white balance. We took a picture of the hands after every 10 fragments of asexual coral propagation. Finally, the degree of blackening of the hands in the pictures was measured by RGB values. Many image-editing software programs can be used to evaluate RGB values in photos. We used Microsoft Paint because it is a free built-in program in the Windows operating system (from Win XP to Win 10, Microsoft Corporation, Redmond, CA, USA) and is easy to operate. First, we opened the photo files in Microsoft Paint, clicked on the “Color Picker” button in Tools, and then clicked on the blackest point of the fingertip in the photo. Second, we clicked on the ‘’Edit Colors’’ button in Colors, then a new window appeared. The lower-right corner of the new window showed the values of red, green, and blue colors. For more details, please refer to the video at https://www.youtube.com/watch?v=FX17dmqcVds (accessed on 1 June 2022).
2.3. Coral Culture and Maintenance
S. flexibilis, S. brassica, S. sandensis, S. compressa, and Klyxum simplex have been cultured in the husbandry center of the NMMBA for many years. The corals are maintained under a natural photoperiod in an eight-ton outdoor aquarium with flow-through seawater. The temperature in the tank is maintained at 26 ± 1 °C by a microprocessor-controlled cooler.
2.4. Collecting the Black Pigment Released from S. flexibilis
The tentacles of S. flexibilis were cut into 1 cm pieces and incubated in FSW (36‰) or high-salinity FSW (60‰) overnight. Both the fragments incubated in FSW (36‰) and high-salinity FSW (60‰) released black pigment into the water. The black solution was then filtered by a 70 µm cell strainer to remove large tissues. Then the filtered black solution was centrifuged at 20,000 rpm for 5 min to collect the black pellets. After removing the supernatant, freshwater was added into the centrifuge tube to resuspend the black pellets, which were then incubated for 30 min to break down the Symbiodiniaceae. The black pigment was collected from the bottom of the tube after being centrifuged at 20,000 rpm for 5 min and removing the supernatant.
3. Results
3.1. Asexual Propagation Process of the Octocoral S. flexibilis
In NMMBA’s husbandry center, we culture corals from more than 35 species and have over 27,500 colonies for research. When performing asexual coral propagation, a donor coral colony is cut into smaller parts. The parts are then attached to an artificial substrate such as tiles [2]. When we were operating the asexual propagation of the octocoral S. flexibilis and were cutting the donor corals into small fragments, we observed that these corals secreted a copious amount of mucus and became very slippery. We put these fragments in a floating basket with flowing seawater to wash out the mucus and let the coral wound heal (Figure 1a). After 1–2 weeks, these coral fragments were attached to the tiles (2 cm × 2 cm) with sewing threads (Figure 1b). The detailed process of fixing the corals to the tiles is presented in the Supplementary Data (Video S1). With this approach, the survival rates of S. flexibilis can reach 90%. The color of the wounds, both newly cut (Figure 1c) and two weeks later (Figure 1d), remained the same and did not turn black.

Figure 1.
Asexual propagation process of the octocoral S. flexibilis: (a) The corals were sliced into small fragments by blade and were left to heal; (b) after 10 days, the small coral fragments were attached to tiles with sewing thread; (c) the newly cut wounds of the corals; (d) two weeks after being cut, the wounds gradually healed. The dotted yellow circles show the wound.
3.2. Skin Dyed Black after Operating Asexual Propagation of S. flexibilis
After touching the slippery fragments of S. flexibilis, the operator’s hands gradually turned black (Figure 2) and became even darker after contacting more coral fragments. We found this phenomenon fascinating and tried to quantify the process of darkening. While the operator performed the asexual propagation of S. flexibilis, we took pictures of the hands after every 10 fragments were processed. The more fragments he touched, the darker his hands became (Figure 2). The operator’s hands did not become black entirely; only the fingertips that touched the corals did. We quantified the degree of blackening of the thumb in Figure 2 with RGB values (Figure 3). The RGB values did not change significantly after operating 60 fragments. We also recorded the blackening of all ten fingers after processing 190 fragments (Figure 4) and quantified their blackness with RGB values (Figure 5). We found that the fingers that touched more corals turned darker (Figure 3 and Figure 5). The longer the coral was in contact with the skin, the darker it became. Additionally, the stain could not be washed away with soap and would only disappear by waiting for the stratum corneum of the skin to fall off naturally. The black pigment on the skin could not be dissolved in water nor removed by detergent.

Figure 2.
The process of dyeing the hands: After operating (a) 0; (b) 20; (c) 40; (d) 60; (e) 80; and (f) 190 fragments of asexual propagation of S. flexibilis, the hands became gradually darker.

Figure 3.
Quantification of the blackening of the left thumb as indicated by the RGB values after propagating S. flexibilis. The horizontal color bar at the bottom is the color of the sum of the RGB values.

Figure 4.
After operating 190 fragments for the asexual propagation of S. flexibilis, (a) the left hand and (b) the right hand became black.

Figure 5.
Quantification of the blackening of the fingertips as indicated by the RGB values after propagating 190 fragments of S. flexibilis. The horizontal color bar at the bottom is the color of the sum of the RGB values.
3.3. High-Salinity FSW Incubation Increased the Amount of Black Pigment Released
When touching an undamaged colony of S. flexibilis, the operator’s hands were not stained. Only by touching the wounded fragments of the coral did the hands become black. Therefore, we hypothesized that increasing the contact area of the coral wounds with seawater and increasing the stress of the corals would increase the amount of black pigment released. We cut off three tentacles of S. flexibilis. One was incubated in FSW (36‰) as the control (Figure 6a) and the other two were cut into small pieces and incubated in FSW (36‰) (Figure 6b) and high-salinity FSW (60‰) (Figure 6c) in 6-well plates. After 4 h, the tentacle in the high-salinity FSW (60‰) released the highest amount of black pigment (Figure 6f), second was the tentacle in the FSW (36‰) (Figure 6e), and the uncut tentacle released almost none (Figure 6d). Some of the black pigment adhered to the surface of the tentacles (Figure 6h,i) but most were released into the solution, which turned it black (Figure 6j,k). In Figure 6b,c, the brown color of the solution was caused by the released zooxanthellae from the coral wound and not the black pigment, as confirmed by microscopy (data not shown).

Figure 6.
The process of black pigment being released from the coral tentacles into seawater. (a–c) The tentacles of S. flexibilis were collected in 6-well plates; (a,d) a complete tentacle; (b,e) small pieces of tentacles incubated in FSW (36‰); (c,f) small pieces of tentacles incubated in high-salinity FSW (60‰). After 4 h, the corals and black pigment were observed by (d–f) phone camera and (g–k) microscopy, with the white bar representing 1 mm; (g–i) are the magnified images of the tentacles in the blue box in (d–f), respectively; (j,k) the enlarged image of the black pigment released into the solution in (e,f), respectively.
3.4. No Octocorals Apart from S. flexibilis Released Black Pigment
In the NMMBA, we operate asexual propagation on more than eight species of octocorals and only S. flexibilis was found to have stained the operator’s hands black after touching their fragments. Therefore, we chose five species of octocorals to confirm that only S. flexibilis can release black pigment. Tentacles about 1 cm long were collected from these five species and put into 6-well plates (Figure 7a–e). Then, they were cut into smaller pieces and incubated in FSW (36‰) overnight (Figure 7f–j). After 20 h, only S. flexibilis released black pigment and turned the solution black (Figure 7k). The others were observed to have only released brown zooxanthellae into the solution (Figure 7l–o). This experiment confirmed that only S. flexibilis releases black pigment, which coincided with the results of the asexual propagation of the corals.
Figure 7.
The amount of black pigment released by different kinds of octocorals. (a–e) Tentacles about 1 cm long from five different species of octocorals were collected in 6-well plates; (f–j) these octocorals were cut into small pieces and incubated in FSW (36‰); (k–o) after 20 h, the amounts of black pigment were observed. (a,f,k) S. flexibilis; (b,g,l) S. brassica; (c,h,m) S. sandensis; (d,i,n) S. compressa; (e,j,o) Klyxum simplex.
3.5. Characteristics of the Black Pigment
We learned from the above experiments that one of the properties of S. flexibilis’ black pigment is its insolubility in FSW. We could collect a large amount of the black pigment by cutting tentacles of S. flexibilis into small pieces and incubating them in high-salinity FSW (60‰) (Figure 6f) overnight and obtain the black pigment pellets via centrifugation (Figure 8a). However, we found it difficult to collect 100% of the pure black pigment because it was a very sticky substance and was entangled with Symbiodiniaceae. We attempted to break down the Symbiodiniaceae and remove them by adding pure water, but that was ineffective. The black pigment pellets were still contaminated with a few Symbiodiniaceae (Figure 8b). Furthermore, we tried five different solvents to dissolve the pellets, namely, methanol, acetone, toluene, ethyl acetate, and dimethyl sulfoxide, but all failed. Thus, we were unable to dissolve the pigment or identify its structure.

Figure 8.
Observation of the collected black precipitate with the naked eye and with a microscope. (a) Black pigment released from S. flexibilis was collected from the bottom of a 1.5 mL centrifuge tube; (b) the black pigment entangled with Symbiodiniaceae (brown spheres) as observed under microscopy.
4. Discussion
Marine organisms are potential sources of natural pigments that are useful substitutes for existing synthetic or land-organism pigments in various fields, such as food, cosmetic, and pharmaceutical industries, because of their excellent biocompatibility, safety, and stability [13]. Algae, microorganisms, and animals are major pigment sources in marine environments. Furthermore, these metabolites can be classified into eight major classes: chlorophylls, carotenoids, phycobiliproteins, tetrapyrroles, quinones, azulenes, indigoids, and melanin [10,13]. Melanin is a group of complex, natural, and dark-colored pigments [11,14,15,16]. It plays multiple roles [17,18] in the field of biomedicine and biological functions [19,20]. It is also a very promising drug due to its good biocompatibility and biodegradability [21]. Thus, finding new sources of black pigment in cultured marine animals may be a promising alternative for producing sustainable melanin. However, the extraction and purification of melanin are highly dependent on the source. Since melanin is always bound to other cellular components, it can be a challenging task to isolate pure melanin [22]. Previous studies found that corals not only have chlorophyll-a and carotenoid pigments from symbiotic dinoflagellates [23] but also can perform melanin synthesis to put up a cytotoxic defense, form a protective barrier, and provide structural support [5]. The coagulation pathway also induces clot formation to seal wounds and prevent infections [24]. Although corals can produce melanin in the tissues, no report has mentioned that they can release melanin into a solution. In this study, we found aquaculture corals can produce black pigments in the tissues and they are insoluble in five common organic solvents (methanol, acetone, toluene, ethyl acetate, and dimethyl sulfoxide) and water. This article is the first to report that corals can release a black pigment that dyes the human skin black. Moreover, this black pigment can be continuously collected through coral aquaculture.
Although the chemical structure of S. flexibilis’ black pigment is still not clear, the chemical characterization of the pigment is similar to that of melanin. Melanin is a mixture of different tyrosine derivatives [25]. Marine invertebrates, such as sea cucumbers and cephalopods, also produce melanin [11]. A previous study used the alkali-soluble acid precipitation method to purify melanin and was able to solubilize sepia melanin with 10 M NaOH and precipitate the melanin with 5 M HCl [26]. To purify sea cucumber melanin, researchers have also used NaOH to dissolve the melanin and then adjusted the pH of the supernatant to about 2.0 to precipitate the melanin [27]. These approaches inspired us (as we encountered obstacles in our attempt to dissolve the octocoral’s black pigment) to conduct a follow-up study in the future to mix different solvents or adjust the pH values of the solutions to dissolve it. Doing so will enable us to obtain liquid samples needed for spectroscopic experiments that will give us insight into the structure of the black pigment released from S. flexibilis. The structure and function of the black pigment merit further study, as it has the potential to become a new black dye or drug for humans.
Supplementary Materials
The following supporting information can be downloaded at: https://www.mdpi.com/article/10.3390/app12168012/s1, Video S1: The detailed process of fixing corals to tiles.
Author Contributions
Conceptualization, H.-H.L.; methodology, H.-H.L., Y.-C.C. and F.-W.K.; investigation, H.-H.L. and F.-W.K.; resources, H.-H.L., Y.-C.C. and F.-W.K.; data curation, H.-H.L., Y.-C.C. and F.-W.K.; writing—original draft preparation, H.-H.L.; writing—review and editing, H.-H.L. and F.-W.K.; visualization, H.-H.L. and F.-W.K.; supervision, H.-H.L.; project administration, H.-H.L.; funding acquisition, H.-H.L. All authors have read and agreed to the published version of the manuscript.
Funding
This research received no external funding.
Institutional Review Board Statement
Not applicable.
Informed Consent Statement
Not applicable.
Conflicts of Interest
The authors declare no conflict of interest.
References
- Stella, J.S.; Pratchett, M.S.; Hutchings, P.A.; Jones, G.P. Coral-associated invertebrates: Diversity, ecology importance and vulnerability to disturbance. Oceanogr. Mar. Biol. 2011, 49, 43–104. [Google Scholar]
- Barton, J.A.; Willis, B.L.; Hutson, K.S. Coral propagation: A review of techniques for ornamental trade and reef restoration. Rev. Aquac. 2015, 9, 238–256. [Google Scholar] [CrossRef]
- Fusetani, N.; Matsunaga, S.; Konosu, S. Bioactive marine metabolites I. Isolation of guaiazulene from the gorgonian Euplexaura erecta. Experientia 1981, 37, 680–681. [Google Scholar]
- Imre, S.; Thomson, R.H.; Yalhi, B. Linderazulene, a new naturally occurring pigment from the gorgonian Paramuricea chamaeleon. Experientia 1981, 37, 442–443. [Google Scholar] [CrossRef]
- Söderhäll, K.; Smith, V.J. The prophenoloxidase activating system: The biochemistry of its activation and role in arthropod cellular immunity, with special reference to crustaceans. In Immunity in Invertebrates; Springer: Berlin/Heidelberg, Germany; New York, NY, USA; Tokyo, Japan, 1986; pp. 208–223. [Google Scholar] [CrossRef]
- Sakemi, S.; Higa, T. 2,3-Dihydrolinderazulene, a new bioactive azulene pigment from the gorgonian Acalycigorgia sp. Experientia 1987, 43, 624–625. [Google Scholar] [CrossRef] [PubMed]
- Zagalsky, P.F.; Haxo, F.; Hertzberg, S.; Liaaen-Jensen, S. Studies on a blue carotenoprotein, linckiacyanin, isolated from the starfish Linckia laevigata (Echinodermata: Asteroidea). Comp. Biochem. Physiol. Part B Comp. Biochem. 1989, 93, 339–353. [Google Scholar] [CrossRef]
- Naegel, L.C.A.; Cooksey, C.J. Tyrian Purple from marine muricids, especially from Plicopurpura pansa (Gould, 1853). J. Shellfish Res. 2002, 21, 193–200. [Google Scholar]
- Xie, S.; Guo, C.; Liu, F.; Liang, X. Purification and characterization of vitellin in mature ovary of marine crab Charybdis japonica. Chin. J. Oceanol. Limnol. 2008, 26, 162–165. [Google Scholar] [CrossRef]
- Pereira, D.M.; Valentão, P.; Andrade, P.B. Marine natural pigments: Chemistry, distribution and analysis. Dye. Pigm. 2014, 111, 124–134. [Google Scholar] [CrossRef]
- Ghattavi, K.; Homaei, A.; Kamrani, E.; Kim, S.-K. Melanin pigment derived from marine organisms and its industrial applications. Dye. Pigm. 2022, 201, 110214. [Google Scholar] [CrossRef]
- Palmer, C.V.; Baird, A.H. Coral tumor-like growth anomalies induce an immune response and reduce fecundity. Dis. Aquat. Org. 2018, 130, 77–81. [Google Scholar] [CrossRef] [Green Version]
- Manivasagan, P.; Bharathiraja, S.; Santha Moorthy, M.; Mondal, S.; Seo, H.; Dae Lee, K.; Oh, J. Marine natural pigments as potential sources for therapeutic applications. Crit. Rev. Biotechnol. 2018, 38, 745–761. [Google Scholar] [CrossRef] [PubMed]
- Araujo, M.; Viveiros, R.; Correia, T.R.; Correia, I.J.; Bonifacio, V.D.; Casimiro, T.; Aguiar-Ricardo, A. Natural melanin: A potential pH-responsive drug release device. Int. J. Pharm. 2014, 469, 140–145. [Google Scholar] [CrossRef] [PubMed]
- d’Ischia, M.; Wakamatsu, K.; Cicoira, F.; Di Mauro, E.; Garcia-Borron, J.C.; Commo, S.; Galvan, I.; Ghanem, G.; Kenzo, K.; Meredith, P.; et al. Melanins and melanogenesis: From pigment cells to human health and technological applications. Pigment Cell Melanoma Res. 2015, 28, 520–544. [Google Scholar] [CrossRef] [Green Version]
- Wold, C.W.; Gerwick, W.H.; Wangensteen, H.; Inngjerdingen, K.T. Bioactive triterpenoids and water-soluble melanin from Inonotus obliquus (Chaga) with immunomodulatory activity. J. Funct. Foods 2020, 71, 104025. [Google Scholar] [CrossRef]
- Simon, J.D. Spectroscopic and dynamic studies of the epidermal chromophores trans-urocanic acid and eumelanin. Acc. Chem. Res. 2000, 33, 307–313. [Google Scholar] [CrossRef] [PubMed]
- Singh, S.; Nimse, S.B.; Mathew, D.E.; Dhimmar, A.; Sahastrabudhe, H.; Gajjar, A.; Ghadge, V.A.; Kumar, P.; Shinde, P.B. Microbial melanin: Recent advances in biosynthesis, extraction, characterization, and applications. Biotechnol. Adv. 2021, 53, 107773. [Google Scholar] [CrossRef] [PubMed]
- Shanmuganathan, K.; Cho, J.H.; Iyer, P.; Baranowitz, S.; Ellison, C.J. Thermooxidative stabilization of polymers using natural and synthetic melanins. Macromolecules 2011, 44, 9499–9507. [Google Scholar] [CrossRef]
- Solano, F. Melanin and melanin-related polymers as materials with biomedical and biotechnological applications-cuttlefish ink and mussel foot proteins as inspired biomolecules. Int. J. Mol. Sci. 2017, 18, 1561. [Google Scholar] [CrossRef] [PubMed]
- Eom, T.; Woo, K.; Shim, B.S. Melanin: A naturally existing multifunctional material. Appl. Chem. Eng. 2016, 27, 115–122. [Google Scholar] [CrossRef] [Green Version]
- Pralea, I.E.; Moldovan, R.C.; Petrache, A.M.; Ilies, M.; Heghes, S.C.; Ielciu, I.; Nicoara, R.; Moldovan, M.; Ene, M.; Radu, M.; et al. From extraction to advanced analytical methods: The challenges of melanin analysis. Int. J. Mol. Sci. 2019, 20, 3943. [Google Scholar] [CrossRef] [PubMed] [Green Version]
- Khalesi, M.K.; Lamers, P. Partial quantification of pigments extracted from the zooxanthellate octocoral Sinularia flexibilis at varying irradiances. Biologia 2010, 65, 681–687. [Google Scholar] [CrossRef]
- Theopold, U.; Schmidt, O.; Soderhall, K.; Dushay, M.S. Coagulation in arthropods: Defence, wound closure and healing. Trends Immunol. 2004, 25, 289–294. [Google Scholar] [CrossRef]
- Ferraz, A.R.; Pacheco, R.; Vaz, P.D.; Pintado, C.S.; Ascensão, L.; Serralheiro, M.L. Melanin: Production from cheese bacteria, chemical characterization, and biological activities. Int. J. Environ. Res. Public Health 2021, 18, 10562. [Google Scholar] [CrossRef] [PubMed]
- Panzarasa, G.; Osypova, A.; Consolati, G.; Quasso, F.; Soliveri, G.; Ribera, J.; Schwarze, F.W.M.R. Preparation of a sepia melanin and poly(ethylene-alt-maleic anhydride) hybrid material as an adsorbent for water purification. Nanomaterials 2018, 8, 54. [Google Scholar] [CrossRef] [Green Version]
- Li, X.; Wang, J.; Liu, H.; Chen, L.; Jiang, A. Comparison of structure and properties of sea cucumber melanin before and after degrdation. J. Biotech Res. 2019, 10, 283–292. [Google Scholar]
Publisher’s Note: MDPI stays neutral with regard to jurisdictional claims in published maps and institutional affiliations. |
© 2022 by the authors. Licensee MDPI, Basel, Switzerland. This article is an open access article distributed under the terms and conditions of the Creative Commons Attribution (CC BY) license (https://creativecommons.org/licenses/by/4.0/).